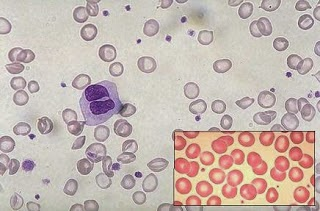

ANEMIAS CARENCIAIS
A Organização Mundial de Saúde (OMS) define anemia como a condição na qual os níveis de hemoglobina se encontram abaixo do valor de referência de acordo com o sexo, faixa etária, estado fisiológico e altitude.
ANEMIAS CARENCIAS
DEFINIÇÃO:
ANEMIAS PROVOCADAS PELA CARÊNCIA DE NUTRIENTES.
EXEMPLOS:
- ANEMIA POR CARÊNCIA DE FERRO.
- ANEMIA POR CARÊNCIA DE VITAMINAS (B12 E B9 "ÁCIDO FÓLICO")
SINTOMAS APRESENTADOS POR PACIENTES COM ANEMIA
- Fraqueza
- Cefaleia
- Irritabilidade
- Fadiga
- Intolerância aos exercícios
- Pica (apetite pervertido por barro ou terra, papeis, amido)

-
Anemia causada pela diminuição dos estoques de ferro a níveis que comprometem a síntese de hemoglobina e a eritropoese.
-
Causa mais comum de anemia em todo o mundo.
IMPORTÂNCIA DO FERRO PARA O ORGANISMO
Participa de múltiplos processos vitais variando desde mecanismos celulares oxidativo até transporte de oxigênio nos tecidos.
É um componente fundamental de moléculas como hemoglobina, mioglobina, citocromos, e inúmeras enzimas, além das proteínas próprias de seu metabolismo.

DIAGNÓSTICO LABORATORIAL DE ANEMIA FERROPRIVA
- HEMOGRAMA ( com os índices hematimétricos e avaliação de esfregaço periférico).
- DOSAGEM DE FERRITINA.
- Dosagem de ferro sérico, transferrina e a saturação da transferrina não são obrigatórios.
HEMOGRAMA

HEMOGRAMA
Achados:
Hemoglobina (Hb): (7 a 12 g/ dL) anemia leve e moderada, (<7 g/dL) anemia grave
Hipocromia
Microcitose
Anisocitose (RDW elevado >16%)

ESFREGAÇO SANGUÍNEO PARA ANÁLISE MORFOLÓGICA DAS CÉLULAS
HEMOGRAMA
FERRITINA SÉRICA
A concentração da ferritina sérica (FS) é o mais confiável marcador das reservas de ferro do corpo, substituindo a avaliação da medula óssea realizada anteriormente. Os valores normais variam de 40 a 200 ng/mL (mcg/L)

ESTUDO DE CASO

ESTUDO DE CASO
Perguntas:
1) Como você faria a interpretação dos resultados laboratoriais?
2) Como você explicaria as causas da anemia?
ANEMIA POR CARÊNCIA DE VITAMINA B12 E B9 (ÁCIDO FÓLICO)
OU
MEGALOBLÁSTICA
ANEMIA POR CARÊNCIA DE VITAMINA B12 E B9 (ÁCIDO FÓLICO)
Vitamina B12 (cianocobalamina) e Vitamina B9 (ácido fólico) atuam como coenzimas em reações que ocorrem na síntese de DNA.

Vitamina B12

Vitamina B9
ANEMIA POR CARÊNCIA DE VITAMINA B12 E B9 (ÁCIDO FÓLICO)
É, portanto, um distúrbio, ocasionado por uma alteração na síntese do DNA que se caracteriza por um estado em que a divisão celular se torna lenta, a despeito do crescimento citoplasmático. Esta anormalidade nada mais é do que uma assincronia da maturação do núcleo em relação ao citoplasma. As células se preparam para uma divisão que não ocorre, e, como resultado, acabam se tornando maiores.
CAUSAS DA ANEMIA MEGALOBLÁSTICA


MANIFESTAÇÕES CLÍNICAS DA DEFICIÊNCIA DE VITAMINA B12
São polimórficas, variando de estados mais brandos até condições muito severas.
Quadro clássico é caracterizado por anemia megaloblástica associada a sintomas neurológicos com frequente aparecimento da tríade fraqueza, glossite e parestesias.



MANIFESTAÇÕES CLÍNICAS DA DEFICIÊNCIA DE VITAMINA B9
Glossite, anemia megaloblástica indistinguível da anemia megaloblástica causada pela deficiência de vitamina B12.
No entanto, não se observa as alterações neurológicas típicas da deficiência de vitamina B12.
ACHADOS LABORATORIAIS ANEMIA POR CARÊNCIA DE VITAMINA B12 E B9
Nas anemias por deficiência de vitamina B12 e/ou ácido fólico, o VCM é superior a 110fL e não há reticulocitose, constituindo assim em anemia megaloblástica.
Além de ser observado uma hipersegmentação do núcleo dos neutrófilos.


ANEMIA MEGALOBLÁSTICA
CASO CLÍNICO
CASO CLÍNICO
Text

Hemoglobina: 11,5 a 16,4 g/dL
Hematócrito: 36 a 47%
Hemácias: 3,9 a 5,6 milhões/mm3
VCM: 76 a 96 fL
Leucócitos: 4.000 a 10.000/mm3
Plaquetas: 150.000 a 450.000/mm3
Valores de referência:
Trabalho para próxima aula...
Em grupo, realizar pesquisa de doenças crônicas que podem levar o aparecimento de anemia.
Caracterizando o quadro clínico de "anemia de doença crônica"
ANEMIAS CARENCIAIS
By KELLY EMI HIRAI
ANEMIAS CARENCIAIS
- 1,812